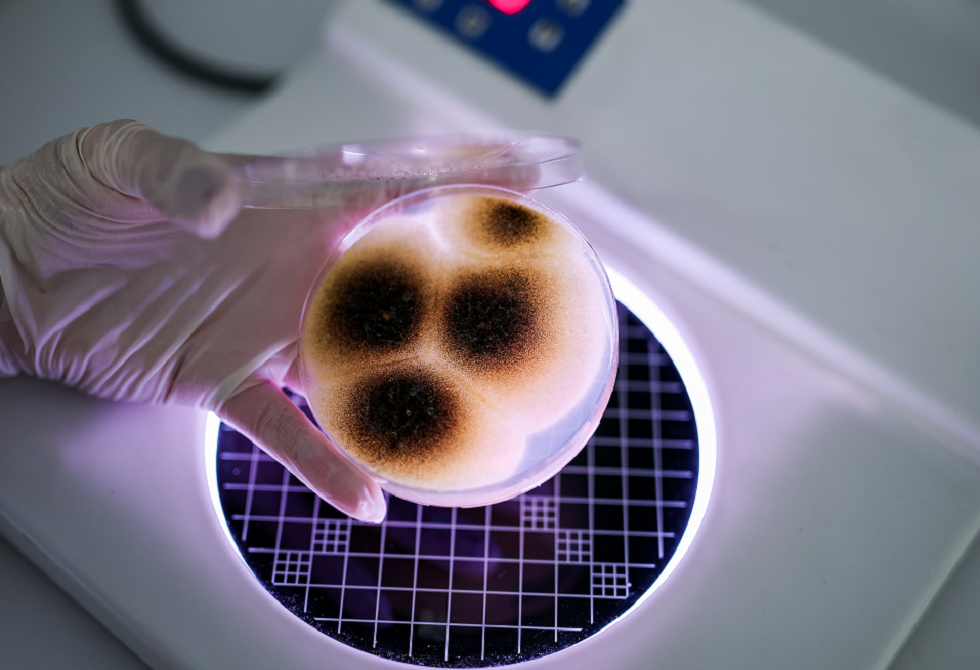

- هام حول تحويل الأموال من حساب إلى آخر عبر بريدي موب – النهار أونلاين
- الاحتلال يوسع الخط الأصفر في عمق غزة وينسف عشرات المباني خارجه
- الوزير عرقاب يسلّم رسالة من الرئيس تبون إلى رئيس تشاد
- وزارة الاتصال توجه إعذاراً ليومية "الوطن" إثر نشر خبر مغلوط حول قانون المرور – النهار أونلاين
- السودان بعد ألف يوم من الحرب- أزمة إنسانية مأساوية وصمت دولي
- إليكم ما نعرفه عن الاجتماع الثنائي بين ترامب وزيلينسكي في دافوس
- مدرب السنغال يبرر فوضى نهائي أمم أفريقيا.. هذا ما قاله
- تحويل الأموال بين الحسابات البريدية أصبح أسهل عبر “بريدي موب”.. هذه شروط الاستفادة
- نقل بحري.. هذه هي مواعيد التسجيل لرحلتي وهران–مرسيليا ومرسيليا–وهران – النهار أونلاين
- عرقاب يُسلم رسالة خطية من الرئيس تبون إلى نظيره التشادي – النهار أونلاين
- كوشنر يعرض خطته لبناء "غزة الجديدة" على مجلس السلام
- المبعوث الأمريكي يلتقي زعيم قسد ودمشق تحذر من انهيار الهدنة
- بوتين: روسيا مستعدة لتقديم مليار دولار لـ "مجلس السلام"
- مسلحون داخل المحاكم.. مخاوف من قضاء تحت الترهيب في السودان
- ألمانيا تطرد دبلوماسياً روسياً بتهمة التجسس.. وموسكو: "استفزاز سخيف"
- من سوريا إلى العراق: ماذا نعرف عن ملف نقل محتجزي تنظيم الدولة الإسلامية وتداعياته؟
- تعذيب واغتصاب.. هل تغلق مدرسة "بيتارام" الكاثوليكية أبوابها في فرنسا؟
- مسؤولون أوروبيون: ملف غرينلاند لم يحسم بعد
كيف نجح الشرع بسحب الحماية الأمريكية من قسد؟ وما مستقبل أكراد المنطقة؟
في حال واجهت مشكلة في مشاهدة الفيديو، إضغط على رابط المصدر للمشاهدة على الموقع الرسمي
"أنا أحب الأكراد، لكن فقط لكي تفهموا، دُفعت مبالغ هائلة من المال لهم، ومُنحوا النفط وأشياء أخرى. لذلك كانوا يفعلون ذلك من أجل أنفسهم، أكثر مما يفعلونه من أجلنا، لكننا متوافقون معهم، ونحاول حمايتهم"
خرجت هذه الكلمات من الرئيس الأمريكي دونالد ترمب في البيت الأبيض خلال مؤتمره الصحفي بمناسبة مرور عام على بدء فترة حكمه الثانية والأخيرة وفق الدستور.
وقبل ذلك بعدة ساعات قال صديقه القديم، ومبعوثه إلى سوريا، توم براك، إن الغرض الأصلي لقوات سوريا الديمقراطية (قسد) -كقوة رئيسية لمكافحة تنظيم الدولة الإسلامية (داعش)- قد انتهى على الأرض، مشيرا إلى أن هذه اللحظة تتيح مسارا نحو الاندماج الكامل في دولة سورية موحّدة مع ضمان حقوق المواطنة.
اقرأ أيضا
list of 2 items* list 1 of 2 6 من أقوى الدبابات في العالم
* list 2 of 2 اعترافات أقدم أسير في العالم end of list
كلمات اعتبرها عدد من المعلقين حدأ فاصلا بين عالم قديم ربط واشنطن بالأكراد، وعالم جديد تتشكل فيه علاقات الطرفين بصورة مغايرة لما عرفته خلال العقود الأخيرة، حين سادت علاقاتٌ عدائية بين واشنطن ونُظُمِ الحكم في كل من بغداد ودمشق.
ولم تتطوَر العلاقات الأمريكية بأكراد الدولتين بمعزل عن طبيعة علاقات واشنطن بالحكومة المركزية؛ فمن خلال النظر إلى هذه العلاقات من زاوية المصالح الأمريكية الأوسع في الشرق الأوسط، يتضح أنها تتغير حاليا بصورة كبيرة وسريعة.
من هنا جاء الموقف الأمريكي مؤخرا من القضية الكردية متمما وعاكسا لتطور لافت في علاقات واشنطن بدمشق منذ انهيار نظام الرئيس المخلوع بشار الأسد في ديسمبر/كانون الأول 2024، ووصول الرئيس أحمد الشرع إلى سُدّة الحكم.
وقد التقى ترمب بالشرع 3 مرات بدأت بقمة في العاصمة السعودية الرياض في مايو/أيار الماضي، ثم لقاء ثانٍ على هامش اجتماعات الجمعية العامة للأمم المتحدة في نيويورك في شهر سبتمبر/أيلول، وانتهت بزيارة تاريخية قام بها الرئيس السوري إلى البيت الأبيض في نوفمبر/تشرين الثاني الماضي.
وأصبح الشرع أول رئيس سوري يزور واشنطن منذ استقلال سوريا عام 1946، وهي الزيارة التي جاءت بعد أيام من شطب اسمه من قوائم الإرهاب الأمريكية والدولية.
علاقات أمريكية كردية ليست بقديمة
لم يكن للولايات المتحدة سياسة مباشرة تجاه الأكراد خلال فترة حكم العثمانيين، أو بعد انهيار حكمهم مباشرة مع تقسيم المناطق الكردية بين 4 دول هي تركيا وإيران والعراق وسوريا.
وبعد الحرب العالمية الأولى، دعمت الولايات المتحدة بصفة عامة مبدأ تقرير المصير على يد الرئيس الأمريكي حينها ودرو ويلسون، وهو ما ألهم القوميين الأكراد، لكن الولايات المتحدة لم تدعم قيام دولة كردستان مستقلة أبدا.
وعلى صفحات دورية "المجلة الدولية للاستخبارات ومكافحة التجسس"، ذكر الأكاديمي فرهنج فريدون، من قسم العلوم السياسية بجامعة ولاية ميزوري، أن وكالة الاستخبارات المركزية (CIA) لطالما عملت تاريخيًّا كوزارة خارجية فعلية للحكومة الأمريكية في المناطق التي لم تنشأ فيها علاقاتٌ دبلوماسية رسمية.
وكان هذا هو الحال مع علاقات الوكالة بالأكراد العراقيين والسوريين؛ حيث تواصل الأكراد مع واشنطن عبر وكالة الاستخبارات المركزية. هذه التفاعلات السياسية والاستخباراتية خلقت حالة من عدم اليقين استمرت حتى اليوم، خاصة في ظل تذبذب موقف واشنطن من تطلعات الأكراد للاستقلال أو حتى الحكم الذاتي.
وكان منطلق تفاعل واشنطن مع مناطق الأكراد في منطقة الشرق الأوسط عبر عدسة الحرب الباردة وصعود المد السوفياتي، إذ أصبح الأكراد في العراق أداة ضغط على بغداد، خاصة عندما تحالف العراق مع الاتحاد السوفياتي.
لكن نظرة تاريخية لتلك العلاقة، تنبئنا أن هدف واشنطن الرئيسي من علاقتهم بالأكراد لم يكن لمنحهم الاستقلال قدر ما كان يصب إستراتيجيا نحو إضعاف الحكومة العراقية.
وجاءت أهم لحظةٍ تأسيسية في العلاقة الكردية الأمريكية عقب حرب الخليج الأولى عام 1991، عندما اندلعت انتفاضات كردية في شمال العراق، وقمعها نظامُ الرئيس السابق صدام حسين بعنف شديد، وأدّى ذلك لاحقا إلى فرض الولايات المتحدة وحلفائها منطقةَ حظر جوي شمال العراق، وهي الحماية التي مكَّنت الأكرادَ من إجراء انتخابات وتشكيل حكومة إقليم كردستان عام 1992.
 مصدر الصورة
مصدر الصورة
ومع غزو الولايات المتحدة للعراق عام 2003، لعبت قوات البشمركة الكردية دورا داعمًا لواشنطن، بينما دعمت الولايات المتحدة إدراج الأكراد في دستور العراق الجديد، وتم اختيار الكردي جلال طالباني، زعيم حزب الاتحاد الوطني الكردستاني، كأول رئيسٍ في عراق ما بعد صدام حسين.
وفي عام 2014، ومع سقوط الموصل في يد تنظيم الدولة الإسلامية، تغيّر المشهد الإستراتيجي بشكل كبير، حيث أصبح إقليمُ كردستان شريكا أساسيا في محاربة التنظيم من عام 2014 إلى عام 2017.
وشهدت هذه الفترة ذروةَ التحالف الأمريكي مع حكومة إقليم كردستان، الذي تميّز بتعاون سياسي ودبلوماسي وعسكري موسَّع، وأعادت هذه المرحلة تشكيل العلاقة بين الأكراد والولايات المتحدة.
وتعاونت الولايات المتحدة مع "قسد" لمحاربة تنظيم الدولة إلى درجة أصبحت معها هذه القواتُ القوةَ البريةَ الأساسية في العمليات العسكرية ضد التنظيم.
وسألت الجزيرة نت البروفيسور غونيش مراد تزكور، مدير برنامج العلاقات الدولية بجامعة ولاية أريزونا، عن تاريخ الدعم الأمريكي لأكراد سوريا في هذه المرحلة، فرد بالقول: "منذ أن حاصر تنظيم الدولة مدينةَ عين العرب ( كوباني) ذات الأغلبية الكردية في خريف 2014، أصبحت الولايات المتحدة أهم داعم لقسد، التي ظهرت تدريجيا من رحم حزب الاتحاد الديمقراطي، الذي تأسس كفرعٍ من حزب العمال الكردستاني عام 2003.
ولم يَكُن الدعمُ الجوي الأمريكي عاملا في تراجع مكاسب تنظيم الدولة فحسب، بل أسس أيضا لحكم "قسد" على جزء كبير من شمال شرق سوريا (وخاصة محافظات الحسكة والرقة ودير الزور) بحلول عام 2017، وتمكّنت من الحصول على تعاون السكان العرب السنّة الذين يسكنون هذه المناطق.
وفي الوقت نفسه، لم يكن هذا التحالف العملي بين قسد والولايات المتحدة يوما ذا طبيعة إستراتيجية. وكما قال دبلوماسي أمريكي كبير في اجتماع مع قادة أكراد عام 2017، فإن "التحالف مؤقتٌ وتكتيكي ويخدم مصالحنا معا". وكانت معارضةُ تركيا لأي حكمٍ ذاتيّ كردي في سوريا تحت قيادة قوات سوريا الديمقراطية (قسد) "عاملًا حاسما في هذا الصدد" بحسب وصفه.
 مصدر الصورة
مصدر الصورة
إستراتيجية أمن قومي أمريكية مختلفة
لا يمكن فصل ما يجري اليوم بين واشنطن و"قسد" عن إستراتيجية الأمن القومي الجديدة لإدارة الرئيس ترمب، والتي أزيح الستار عنها في ديسمبر/كانون الأول الماضي. حيث أشارت الإستراتيجية أن الولايات المتحدة ستركز على نهج يخدم مصالحها الذاتية ويعطي الأولوية للمصالح الاقتصادية الأمريكية، وأمن الطاقة، وفرص لقطاع الأعمال، على حساب أجندات تعزيز الديمقراطية أو قيم حقوق الإنسان.
وفي هذا السياق، تدعو الإستراتيجية إلى قبول الدول الإقليمية وقادتها كما هم، مع تفضيل التعاون الاقتصادي والاستقرار على الأهداف الأيديولوجية السابقة. لذا، من المرجّح أن تعزز الإستراتيجية الجديدة مكانةَ تركيا وسوريا والعراق كدولٍ مستقلةٍ وشركاءَ إقليميين لواشنطن، وهو ما يقلِّل تلقائيّا الدعمَ الأمريكي لقوات قسد في سوريا ولأكراد العراق.
أما بالنسبة لحكومة إقليم كردستان في العراق، فتحافظ واشنطن على توازنٍ دقيقٍ وسط تراجع النزعة الانفصالية لأكراد العراق، مع احتفاظها في الوقت ذاته بعلاقات جيدة مع بغداد ومع حكومة إقليم كردستان.
وعلى مدار تاريخها، دعمت واشنطن الأكراد عندما يتعلَّق الأمر بخدمة أهدافٍ إستراتيجية أوسع لها، لكن هذا الدعم لم يصل في أيٍّ من مراحله إلى دعم استقلالٍ كرديٍّ كامل، مفضِّلة استقرار الدولة القومية، سواء كانت سوريا حاليّا أو العراق قبل ذلك.
وعلى مدى عقود، كانت التنظيمات السياسية الكردية في العراق وسوريا حلفاءَ أقوياء للولايات المتحدة. وبينما استفادوا من الحماية الأمنية الأمريكية لتعزيز حقوقهم السياسية والاقتصادية، فقد لعبوا أيضا دورا أساسيا في مواجهة خصوم واشنطن، وحماية المصالح الإستراتيجية الأمريكية، ومحاربة ما تسميه أمريكا بالإرهاب.
ومع ذلك، جاءت الرعاية الأمريكية بثمن؛ إذ أدى تحوُّل السياسة الخارجية الأمريكية في أكثر من محطة إلى كوارث. ومع تزايد الضغوط لسحب القوات الأمريكية من العراق وسوريا، يبرز قلقٌ حقيقي من أن يصبح حلفاء أمريكا من الأكراد مرة أخرى ضحايا جانبيين للسياسة الأمريكية.
وعن إمكانية استغلال واشنطن نفوذَها لضمان حكم ذاتيّ أو حماية حقيقية للأكراد السوريين ضمن دولةٍ سورية موحدة، قال البروفيسور تزكور للجزيرة نت إنّه "بالنظر إلى التطورات التي جرت في الأيام القليلة الماضية، يتضح أن الولايات المتحدة تنهي الآن تحالفها التكتيكي والتبادلي مع قسد. حيث ظلّ سلاحُ الجو الأمريكي صامتا، بينما حقق الجيش السوري وقواته المساعدة مكاسبَ ميدانية كبيرة؛ لذا أصبح موضوعُ الحكم الذاتي الكردي قديما. صحيح أن حماية حقوق الأكراد السوريين سؤالٌ أكبر اليوم، لكن نفوذَ الولايات المتحدة على الحكومة السورية في هذا الصدد سيكون منخفضًا أيضًا".
وعن مستقبل الوجود العسكري الأمريكي في المناطق الكردية في العراق وسوريا، في ضوء إستراتيجية علاقات واشنطن بتركيا وحساباتِ توازن العلاقات بين الطرفين، قال يريفان سعيد، الخبير في برنامج الشرق الأوسط بالمجلس الأطلسي، للجزيرة نت، إن "واشنطن لم تُحقّق توازنا مستدامًا. حيث غالبا ما تعاملت السياسةُ الأمريكية مع أولويات الأكراد كنقاط قابلة للتفاوض من أجل الحفاظ على العلاقات مع تركيا وإدارة الديناميكيات الإقليمية الأوسع. وقد بدا ذلك، بالنسبة إلى كثير من الأكراد السوريين، وكأنه هجر أكثر منه توازنا".
ويضيف يريفان سعيد أن "هذا النهجُ يحمل تكاليف على المصالح الأمريكية، بإضعاف شريك محلي مُثبَت ضد تنظيم الدولة، ويشجع الفاعلين الأكراد على النظر نحو رعاة آخرين، ويُغذي عدمَ الاستقرار في شمال شرق سوريا من خلال ترك الترتيبات السياسية غيرَ محلولة والضماناتِ الأمنية غيرَ مستقرة".
ويقول يريفان إن "سياسة التضحية باعتبارات أمن الأكراد قد تُسهّل مرحليا في التعامل مع تحفّظات أنقرة على المدى القصير، لكنها تزيد من المخاطر طويلة الأمد، خاصة ما يتعلّق بانخفاض مصداقية الولايات المتحدة لدى شركائها المستقبليين".
ويرى محللون أن الدولة السورية الجديدة قرأت التحولات في المشهد السياسي الأمريكي وفق الإستراتيجية الأمنية التي أعلنتها إدارة ترامب، فقدمت نفسها بوصفها الدولة المركزية التي ستلعب دورا في استقرار المنطقة، وأن هذا لا يمكن أن يتم وثمّة سلاح داخل الدولة منفصل عن اتجاه الدولة الرئيسي، كما أن هذا التحرك السوري ترافق معه خطاب حقوقيّ وسياسي يضمن حقوق الأكراد.
وقد سبق ذلك إعلان سوريا في نوفمبر/تشرين الثاني الماضي انضمامها رسميا إلى التحالف الدولي ضد تنظيم الدولة الإسلامية، وهو اتفاق لم تسع معه دمشق فقط لتحقيق مكاسب إنسانية فقط، بل كانت خطوة لتحقيق مكاسب سياسية تقدّم الإدارة السورية الجديدة بوصفها الجهة الأمنية الأولى في محاربة تنظيم الدولة، وهو ما قرأه محللون في وقتها باعتباره سحبا للبساط من قوات قسد، التي دائما ما قدمت نفسها أنها الطرف الرئيسي في مواجهة التنظيم.
ووفق ما استجد اليوم تغيرات في المشهد السياسي، يبدو أن تلك التحركات المتتالية لدمشق، عززت من المصالح المشتركة بين الشرع وحكومته من جهة وواشنطن من جهة أخرى.
دور تركي حاسم
لطالما عرقلت العلاقاتُ الإستراتيجية بين واشنطن وأنقرة علاقاتِ واشنطن بأكراد المنطقة، حيث عملت الولايات المتحدة على الحفاظ على توازنٍ دقيقٍ بين دعمها لطموح الحكم الذاتي الكردي وشراكاتها الإستراتيجية مع تركيا.
وكانت سنة 2018 فاصلةً في تحديد بوصلة تركيا تجاه حدودها الجنوبية وعلاقتها بأكراد سوريا. فمع سيطرة إيران وروسيا على النظام السوري السابق، إضافةً إلى تمدّد القوات الكردية التي تراها أنقرة امتدادًا لحزب العمال الكردستاني (PKK) المصنَّف تركيًّا "تنظيما إرهابيا"، والمتمثّل في وحدات حماية الشعب، وتمتّعه بدعم سياسي وعسكري واستخباراتي أمريكي؛ استطاعت تركيا تغيير هذا الواقع في ميزان القوى.
حوّلت أنقرة هذا التطويق شبه الكامل إلى نجاحٍ جيوسياسيٍّ شامل، من خلال نجاحها تدريجيًّا في تفكيك كلا التهديدين دون إشعال حربٍ مباشرة مع أي دولة. فتم احتواء موسكو وطهران عبر مسارات دبلوماسية، وتم تحييد المشروع الكردي المدعوم أمريكيا من خلال الضغط العسكري المستمر والعزلة السياسية.
نظرة للمستقبل
في الوقت ذاته، أكد البروفيسور تزكور للجزيرة نت أن "الولايات المتحدة لا تزال تملك حضورا عسكريا ذا معنى في حكومة إقليم كردستان بالعراق، ويبدو أن هذا سيستمر في المستقبل المنظور. وبالمقارنة، يبدو أن الوجود العسكري الأمريكي في المناطق الكردية في سوريا أقلّ ديمومة؛ اعتمادًا على التطورات على الأرض، بما في ذلك احتمال وقف إطلاق النار، وهو ما يعني أنه لن يكون من المستغرَب رؤية انسحاب كاملٍ للولايات المتحدة من تلك المناطق قبل نهاية هذا العام".
وقد لخص مبعوث ترمب الشخصي إلى سوريا، توم برّاك، بلغة واضحة ومباشرة جوهر موقف بلاده من الأكراد في تغريدةٍ على منصة "إكس"، قال فيها إن أعظم فرصة للأكراد في سوريا تكمن حاليا في ظل الحكومة الجديدة بقيادة الرئيس الشرع، حيث أصبحت دمشق مستعدةً ومؤهَّلةً لتولّي مسؤولية الأمن، بما في ذلك السيطرة على مراكز احتجاز مقاتلي تنظيم الدولة.
وأشار براك إلى أن الوضع تغيّر جذريًّا في سوريا، وأصبحت هناك حكومةٌ مركزيةٌ معترف بها دوليّا، وانتهى الغرض الأصلي لـ"قسد" كقوة لمكافحة تنظيم الدولة.
وقد أكّد براك أنه لا توجد لدى الولايات المتحدة أي مصلحة في وجود عسكريٍّ طويل الأمد في سوريا، وأنها "تضع ضمن أولوياتها هزيمةَ فلول "تنظيم الدولة" ودعمَ المصالحة وتعزيزَ الوحدة الوطنية، دون تبنّي النزعة الانفصالية أو الفيدرالية".
وأضاف برّاك أن هذه اللحظةُ للأكراد تُمثّل مسارا نحو الاندماج الكامل في دولة سورية موحّدة، مع ضمان حقوق المواطنة والحماية الثقافية والمشاركة السياسية، وهو ما أكد عليه الرئيس السوري أحمد الشرع مؤخرا.
وحسب وكالة الأنباء السورية (سانا)، فإن المرسوم الخاص الذي أعلن عنه الرئيس الشرع وقال إنه يضمن حقوق الأكراد وخصوصياتهم لتكون مصونة بنص القانون. ووفق المرسوم الذي يحمل رقم (13) لعام 2026 يؤكد أن المواطنين السوريين الكرد جزء أساسي وأصيل من الشعب السوري، وأن هويتهم الثقافية واللغوية جزء لا يتجزأ من الهوية الوطنية السورية المتعددة والموحّدة.
ويرى مراقبون أن هذا المرسوم سحب البساط من الادعاءات التي ترى أن ما تقوم به الدولة السورية يستهدف الأكراد لذاتهم، في حين أن الرواية السورية تؤكد على الفصل بين قوات قسد كتنظيم مسلح وله أهداف سياسية، وبين الأكراد الذين يمثلون جزءا أصيلا من نسيج المجتمع السوري.
 المصدر:
الجزيرة
المصدر:
الجزيرة